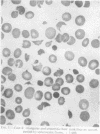
254
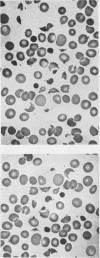
255

Full text
PDF





Images in this article
Selected References
These references are in PubMed. This may not be the complete list of references from this article.
- BRECHER G., CRONKITE E. P. Morphology and enumeration of human blood platelets. J Appl Physiol. 1950 Dec;3(6):365–377. doi: 10.1152/jappl.1950.3.6.365. [DOI] [PubMed] [Google Scholar]
- CALLEN I. R., LIMARZI L. R. Blood and bone marrow studies in renal disease. Am J Clin Pathol. 1950 Jan;20(1):3-23, illust. doi: 10.1093/ajcp/20.1.3. [DOI] [PubMed] [Google Scholar]
- GASSER C., GAUTIER E., STECK A., SIEBENMANN R. E., OECHSLIN R. Hämolytisch-urämische Syndrome: bilaterale Nierenrindennekrosen bei akuten erworbenen hämolytischen Anämien. Schweiz Med Wochenschr. 1955 Sep 20;85(38-39):905–909. [PubMed] [Google Scholar]
- GOLDBLOOM R. B., FISCHER E., REINHOLD J., HSIA D. Y. Y. Studies on the mechanical fragility of erythrocytes. I. Normal values for infants and children. Blood. 1953 Feb;8(2):165–169. [PubMed] [Google Scholar]
- MUIRHEAD E. E., JONES F., STIRMAN J. A., LESCH W. Hemolytic anemia of the dog following bilateral nephrectomy. Am J Physiol. 1953 May;173(2):371–378. doi: 10.1152/ajplegacy.1953.173.2.371. [DOI] [PubMed] [Google Scholar]
- PONDER E., PONDER R. Fragmentation of red cells and ghosts in urea solutions, with a note on electrophoresis patterns. Acta Haematol. 1954 Oct;12(4):282–290. doi: 10.1159/000204630. [DOI] [PubMed] [Google Scholar]
- SCHNEIDERMAN M., BRECHER G. The relative frequency of sparse cell elements--an application to reticulocyte blood counts. Biometrics. 1950 Dec;6(4):390–394. [PubMed] [Google Scholar]
- SCHWARTZ S. O., MOTTO S. A. The diagnostic significance of burr red blood cells. Am J Med Sci. 1949 Nov;218(5):563–566. doi: 10.1097/00000441-194911000-00012. [DOI] [PubMed] [Google Scholar]